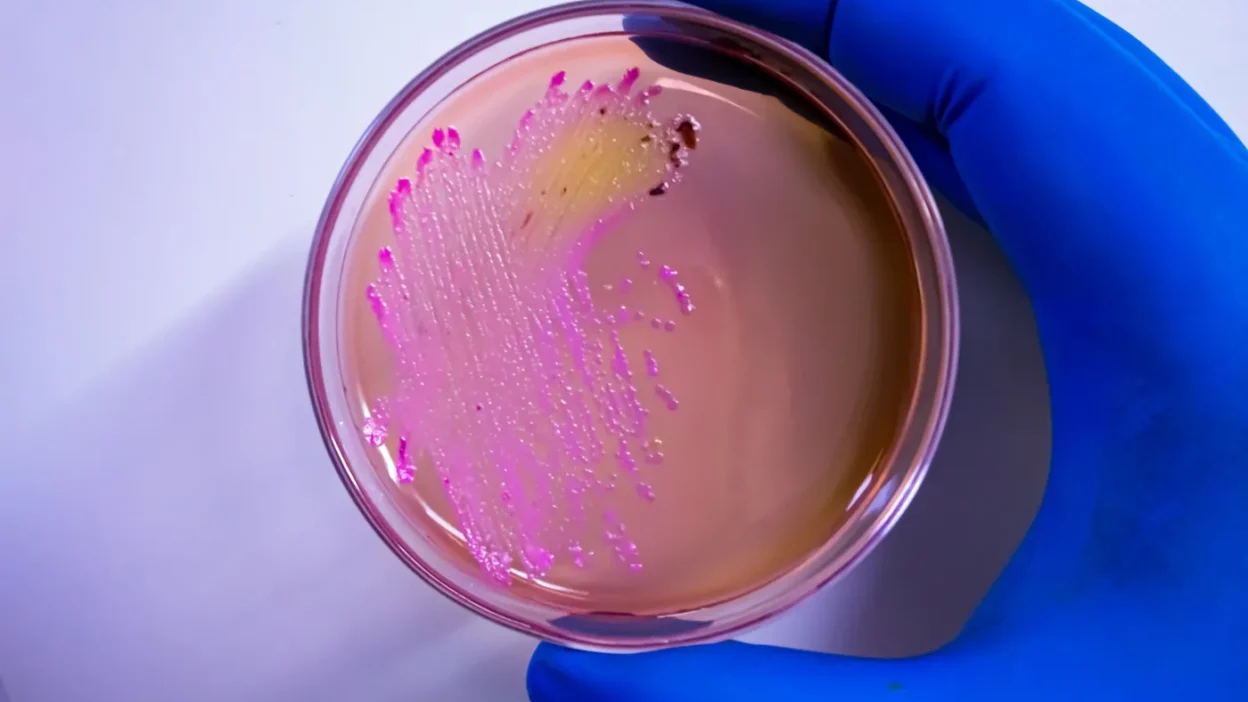

An Argentinian researcher was arrested after stealing dangerous viruses from the University of Campinas (Unicamp) in São Paulo, Brazil.
Virus Theft at Brazilian University
An Argentinian researcher stole dangerous viruses from a laboratory at the University of Campinas (Unicamp) in the Brazilian state of São Paulo, according to Argentinian media citing a police statement. The stolen samples have been recovered.
The samples disappeared from the laboratory in February, but the university only reported the incident this week. Brazilian police have assured the public there is no health risk, as the samples did not leave the university grounds.
Laboratory Security Level
The laboratory from which the material was stolen has a level 3 biological safety rating, meaning research on viruses and bacteria causing serious and airborne diseases is conducted there. The most dangerous pathogens, such as the Ebola virus, require level 4.
Recovered Viral Strains
The recovered material was sent to the Ministry of Agriculture, which has not disclosed the specific pathogens it contained. Brazilian news portal g1 reported the samples included strains of H1N1 and H3N2 influenza viruses, as well as other viruses affecting humans and pigs.
Researcher and Husband Under Investigation
The suspect, 36-year-old Soledad Palameta Miller, specializes in bacteriology, virology, and food safety, and worked at the Institute of Biology at Unicamp. She was arrested but released and will answer charges from a position of freedom.
The researcher’s husband, Michael Edward Miller, a veterinarian and doctoral student at the same university, is also considered a suspect in the case, according to media reports.